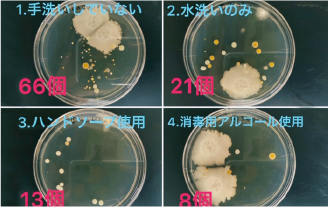

- 現在位置:
- ホーム
- >
- 学科・専攻
- >
- 生活科学学科 食物栄養専攻
- >
- カリキュラム
食物栄養専攻の
カリキュラム
系統立てられたカリキュラム構成により、教養科目・専門科目ともに
二年間でしっかり学ぶことができます。


カリキュラムは2022年度入学生のものです。

PICK UP 授業

-
- 1
- 栄養学実習
- 子どもから高齢者まで、それぞれの特徴をふまえた実習を通して、ライフステージごとの美味しい食事と栄養について考えます。

-
- 2
- 有機化学
- 栄養士となるために欠かせない有機化合物についての知識を、栄養学と結びつけて基礎から学びます。

-
- 3
- 調理学実習Ⅰ・Ⅱ
- 和洋中や世界の料理、行事食などさまざまな調理を行い、食事の目的に合った食卓を演出する能力を身につけます。

-
- 4
- 食品加工実習
- 食品加工学で学んだ内容を活かし、ジャム、ケチャップ、チーズ、豆腐など、さまざまな加工食品を製造します。

-
- 5
- フードコーディネート論
- 料理形態や食事文化、献立構成、食卓の演出、食空間の設計、フードマネージメント、食環境などについて学び、食のコーディネート力を身につけます。

-
- 6
- 給食管理実習
- 約20人のグループで、大量調理をするための厨房機器を使って、約100食分の給食をつくります。つくった給食は1、2年生全員で試食します。

-
- 7
- 解剖生理学実験
- 人体の構造と機能を理解し、健康の保持・増進などにつながる栄養学の実践に不可欠な知識と理論を学びます。

-
- 8
- 運動生理学
- 運動と栄養の関係や運動と健康、特に生活習慣病などの予防に関して学習し、身体活動・運動の意義と必要性を理解します。
-
- 9
- 食品衛生学実験
- 食中毒予防の方法など栄養士に必要な知識と技能を、実験を通して学びます。食の安全確保を実現するために必要な保存法・調理技術および食品衛生検査の原理や効果を理解し、衛生的な食品の取扱い技術を身につけます。
時間割と私のおすすめ授業
実習と実験を重ねて、理解を深めています。

- おすすめ授業 ❶
- 数人ごとのグループで調理に取り組む「調理学実習Ⅰ」。料理の手順を学ぶだけでなく、どのようにメンバーとコミュニケーションを取って動けば良いのか、実践を通じて理解します。
- おすすめ授業 ❷
- 「食品化学実験」は、高校までの授業では見たことも使ったこともないような道具を使って実験を行います。食品や調味料の成分値を細かく知ることができ、知識がどんどん増えていく面白い授業です。
- 空きコマや放課後は...
- 授業中にまとめきれなかったノートの作成に取り組んだり、パソコンを使って課題を進めたりしています。

みずまさん
